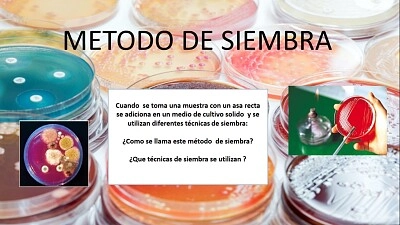

|
||||||||
|
|
||||||||
|
Votre temps 00:00
|
||||||||
|
Temps moyen
00:50
|
||||||||
|
Meilleur temps
01:13
|
||||||||
 |
||||||||
|
|
||||||||
|
||||||||||||||||||||||||||||
BIOTECNOLOGIACe puzzle provient d’un album utilisateur My Album Propriétaire de l’Album : Stephania38
Meilleur Score par : magaly vzla Résolu en :2021-07-15 Crédit photo et copyright :QUIMICA |
||||||
| BIOTECNOLOGIA - 25 Pièces | |||||
| Votre temps: |
|
||||
| Montrer les grosses pièces de puzzle derrière les petites ? Oui Non | |
| Partager ce puzzle |
|
| |